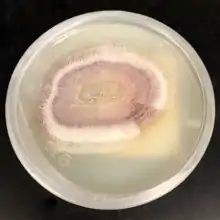

Phaeoacremonium
Phaeoacremonium is a fungus genus associated with wilt and decline diseases of woody hosts and human infections.[1]
| Phaeoacremonium | |
|---|---|
| |
| Phaeoacremonium tardicrescens | |
| Scientific classification | |
| Kingdom: | |
| Phylum: | Anamorphic fungi (Deuteromycota) |
| Class: | (Morphological group) Hyphomycetes |
| Genus: | Phaeoacremonium |
| Type species | |
| Phaeoacremonium parasitica | |
| Species | |
|
See text | |
Togninia is the teleomorph (the sexual reproductive stage) of Phaeoacremonium.[2]
Species
- Phaeoacremonium aleophilum, associated with esca in mature grapevines and decline in young vines (Petri disease), two types of grapevine trunk disease.[3]
- Phaeoacremonium alvesii, a cause of subcutaneous infection of humans [4]
- Phaeoacremonium amstelodamense, a cause of human joint infection[4]
- Phaeoacremonium australiense, an endophyte of grapevines [4]
- Phaeoacremonium griseorubrum, a cause of human fungemia (blood infection)[4]
- Phaeoacremonium krajdenii, a cause of subcutaneous infection of humans[4][5]
- Phaeoacremonium parasitica, formerly Phialophora parasitica[1]
- Phaeoacremonium scolyti, an endophyte of grapevine, also isolated from bark beetle larvae[4]
- Phaeoacremonium sphinctrophorum, from fungal cyst of the human foot[6]
- Phaeoacremonium subulatum, an endophyte of grapevine[4]
- Phaeoacremonium tardicrescens, from unspecified human medical source[4]
- Phaeoacremonium theobromatis, from stem of wild mountain cocoa (Theobroma gileri) in Ecuador[6]
- Phaeoacremonium venezuelense, from eumycetoma of the human foot[4]
References
- Crous, P. W.; Gams, Walter; Wingfield, Michael J.; Van Wyk, P. S. (1996). "Phaeoacremonium gen. nov. associated with wilt and decline diseases of woody hosts and human infections" (PDF). Mycologia. 88 (5): 786–796. doi:10.2307/3760973. hdl:20.500.11755/6d687dfb-743c-4070-b8fa-1161cfc9dd45. JSTOR 3760973.
- Mostert, L; Crous, PW; Ewald Groenewald, JZ; Gams, W; Summerbell, RC (2003). "Togninia (Calosphaeriales) is confirmed as teleomorph of Phaeoacremonium by means of morphology, sexual compatibility and DNA phylogeny". Mycologia. 95 (4): 646–659. doi:10.2307/3761941. JSTOR 3761941. PMID 21148974.
- Martín, M. T.; Cobos, R; Martín, L; López-Enríquez, L (2012). "Real-Time PCR Detection of Phaeomoniella chlamydospora and Phaeoacremonium aleophilum". Applied and Environmental Microbiology. 78 (11): 3985–3991. doi:10.1128/AEM.07360-11. PMC 3346403. PMID 22447605.
- Mostert L, Groenewald JZ, Summerbell RC, et al. (April 2005). "Species of Phaeoacremonium Associated with Infections in Humans and Environmental Reservoirs in Infected Woody Plants". Journal of Clinical Microbiology. 43 (4): 1752–67. doi:10.1128/JCM.43.4.1752-1767.2005. PMC 1081309. PMID 15814996.
- Hemashettar BM, Siddaramappa B, Munjunathaswamy BS, et al. (December 2006). "Phaeoacremonium krajdenii, a cause of white grain eumycetoma". J. Clin. Microbiol. 44 (12): 4619–22. doi:10.1128/JCM.01019-06. PMC 1698411. PMID 17005754.
- Mostert, L.; Groenewald, J. Z.; Summerbell, R. C.; Gams, W.; Crous, P. W. (2006). "Taxonomy and Pathology of Togninia (Diaporthales) and its Phaeoacremonium Anamorphs". Studies in Mycology. 54: 1–113. doi:10.3114/sim.54.1.1.
External links
This article is issued from Wikipedia. The text is licensed under Creative Commons - Attribution - Sharealike. Additional terms may apply for the media files.